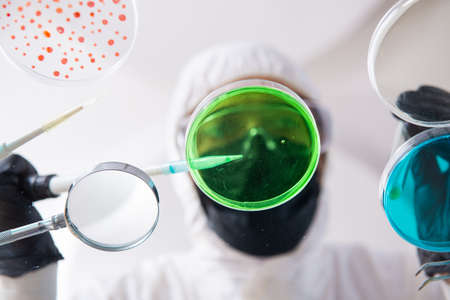
Young chemist working in the labの写真素材

写真素材 - Young chemist working in the lab
キーワード
- analyzing
- bacteria
- biochemical
- biochemist
- biochemistry
- biotechnology
- blood
- chemical
- chemist
- chemistry
- discovery
- dish
- doctor
- epidemic
- examining
- experiment
- experimenting
- flu
- health
- healthcare
- lab
- laboratory
- mask
- medicine
- microbes
- microbiology
- pandemic
- petri
- pharmaceutical
- pharmacology
- pharmacy
- protection
- protective
- research
- researcher
- respirator
- sample
- sars
- scientific
- scientist
- student
- test
- testing
- vaccination
- virology
- virus
類似作品
Portrait of a b...
Blurred of red ...
A frog in a lab...
cute little gir...
Chemical labora...
Scientific equi...
Scientist pipet...
A man stands in...
Science laborat...
Young Asian Sci...
young doctor sc...
Group of chemis...
Chemical labora...
A scientist met...
Modern scientis...
Doctor at farma...
A little scient...
Research, exper...
Blood test in t...
A focused scien...
Young Female Sc...
little schoolbo...
Scientist pipet...
A schoolgirl co...
A vibrant labor...
A professional ...
Double exposure...
Two women condu...
kids with test ...
Scientist pipet...
Little scientis...
Researchers wor...
Laboratory glas...
Doctor at farma...
Scientist pipet...
Researchers wor...
Table full of f...
close up.the sc...
Researchers wor...
Group of childr...
A young scienti...
African-America...
Scientist Looki...
Laboratory glas...
A female scient...
A scientist met...
Researcher usin...
Cute boy is mak...
funny scientist...